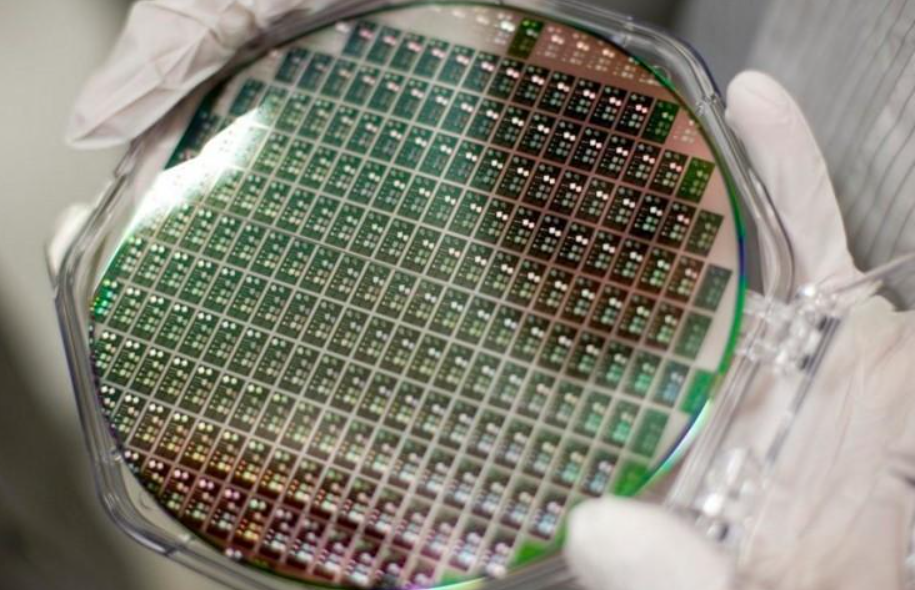

發(fā)布者: 奧卡斯 /  2021-06-08 /
2021-06-08 /  3009 /
3009 /

6月6日,中國銀行業(yè)監(jiān)督管理委員會重點金融機構(gòu)監(jiān)事會主任陳偉鋼在接受采訪時正面回應了此前金融委員會會議上表示打擊比特幣開采的信號。
陳偉鋼指出,實際上早在三年多前就禁止了虛擬貨幣交易,包括比特幣,目前國內(nèi)還沒有任何交易所。國產(chǎn)礦業(yè)仍然難以完全禁止,這一打擊主要針對企業(yè)的礦業(yè)行為。
關(guān)于具體的打擊手段,陳偉鋼表示,可以通過收支方面的財務審計來實現(xiàn)控制,比如企業(yè)挖礦最終肯定會體現(xiàn)為收入、利潤增值,如果部分利潤屬于挖礦,可以不允許企業(yè)入賬,通過這種方式可以封閉企業(yè)的挖礦行為。有些個體購買礦機挖礦,尤其是在一些水力發(fā)電較多的地區(qū),如何封有待下一步觀察。但是砍掉大戶之后,剩下的小戶雖然很多,但總數(shù)并不大。
在5月21日金融委第五十一次會議上,陳偉鋼的這一聲明確提出了打擊比特幣挖礦和交易行為,堅決防范個人風險向社會傳遞,這是首次官方解讀。
在陳偉鋼的解讀中,比特幣不是一種投資產(chǎn)品,而是一種投機產(chǎn)品。在他看來,國外的比特幣交易更多的是機構(gòu)和財團之間的游戲,但在中國主要是散戶投資。就像之前的P2P一樣,其實在英國、美國等國家出現(xiàn)的時間比國內(nèi)早,但是P2P在中國頂峰時參與的人群非常廣泛,這次比特幣投機也是如此。
對外國比特幣交易的合規(guī)化趨勢,陳偉鋼更是坦言,外國能存在的東西并不意味著中國也有合理的存在。
在一定程度上,未來國內(nèi)比特幣礦業(yè)已經(jīng)得出結(jié)論。
打擊比特幣挖掘遇到豐水期。
根據(jù)21世紀經(jīng)濟報道記者了解,盡管監(jiān)管信號明確,但國內(nèi)許多礦工仍然持謹慎觀望態(tài)度,除了內(nèi)蒙古明確退出政策下礦場的轉(zhuǎn)移或關(guān)閉外,新疆、四川、云南等地的許多礦工并沒有急于轉(zhuǎn)移布局。
礦工如此沉著,部分原因是國內(nèi)對比特幣礦業(yè)的整頓并不是第一次。早在2018年初,互聯(lián)網(wǎng)金融風險專項整治辦公室領(lǐng)導小組就發(fā)布了關(guān)于比特幣的通知,提出要積極引導轄區(qū)內(nèi)企業(yè)有序退出采礦業(yè)務,采取電價、土地、稅收、環(huán)保等措施,引導相關(guān)企業(yè)有序退出。
2019年4月9日,國家發(fā)展改革委員會發(fā)表了《產(chǎn)業(yè)結(jié)構(gòu)調(diào)整指導目錄(2019年本,征求意見稿)》,將虛擬貨幣開采活動列為第三類淘汰類第一類落后生產(chǎn)技術(shù)裝備第18條第6款,成為產(chǎn)業(yè)政策明確淘汰的落后生產(chǎn)能力。
但是從那以后,政策有所放松,虛擬貨幣挖掘被移出淘汰類。經(jīng)過多次收緊政策,但虛擬貨幣挖掘至今仍能存活,更有甚者,中國掌握了全球70%以上的比特幣計算能力,是一個名副其實的挖掘大國。
在很多礦工眼里,雖然國家明確提出打擊比特幣開采,但開采本身很難定義為違法行為。目前國家層面還沒有頒布具體實施文件。地方政府除內(nèi)蒙古外,其他省市還沒有頒布明確文件,未來可能會迎來一線轉(zhuǎn)機。
一位比特幣礦工向21世紀經(jīng)濟報道記者指出,礦業(yè)并非完全浪費生產(chǎn)能力,目前許多加密貨幣挖掘地區(qū),如新疆、四川、云南等西北和西南地區(qū),許多地區(qū)地方債務和棄電十分嚴重,比特幣挖掘?qū)ω毨У貐^(qū)的財政、就業(yè)、居民收入等,都有不小的幫助,也有助于新能源設(shè)施的收益,進一步擴大規(guī)模。
另外,從五月份開始,四川已經(jīng)陸續(xù)進入了豐水期。水力發(fā)電在云貴川等水力發(fā)電資源豐富的地區(qū),其豐水期和枯水期的電力供應差異很大,豐水期一度面臨著數(shù)百億度電投產(chǎn)即被拋棄的困境,水力發(fā)電消納一直是四川近年來極力克服的難題。近幾年來,四川許多地市也相繼建立了水力發(fā)電消納產(chǎn)業(yè)示范區(qū),充分利用廢水棄電,在此政策下,高能耗、善遷移的虛擬貨幣挖礦企業(yè)與水力發(fā)電消納需求相匹配,多個大型礦場通過地方政府的招商引資進駐。這一舉措客觀地緩解了四川省水力發(fā)電消納的壓力,2020年四川省水力發(fā)電利用率達到95.4%,完成了國家發(fā)改委、能源局發(fā)布的水力發(fā)電利用率達到95%目標。
另一個豐水期,挖礦企業(yè)是否會在這個時候一刀切。現(xiàn)在四川省還沒有給出明確的答案。
六月二日,四川能源監(jiān)管辦組織召開調(diào)研座談會,充分了解四川虛擬貨幣挖礦的相關(guān)情況。有別于內(nèi)蒙古給出的明確退出、層層加碼的監(jiān)管措施,四川省的座談會主要是征集省內(nèi)電力、能源企業(yè)的意見,沒有作出任何決定。
根據(jù)四川省電力系統(tǒng)內(nèi)部人士透露,四川水力發(fā)電資源豐富,多數(shù)水力發(fā)電企業(yè)并非滿負荷運行,既要考慮民生、電力企業(yè)的實際情況,又不能因虛擬貨幣挖礦活動而產(chǎn)生負面影響。最后的決定還有待統(tǒng)一部署。
二十一世紀經(jīng)濟報道記者在采訪中發(fā)現(xiàn),對于以火力發(fā)電為主的內(nèi)蒙古清理礦業(yè),礦工多有明確的預期,頭部礦場也多有準備。大部分礦工關(guān)注的是四川電力資源豐富的四川省,同時也是算力大省,下一步就是明確的政策。或者將決定國內(nèi)礦業(yè)的下一走向。
礦工候鳥下一步遷移到哪里?
對虛擬貨幣挖礦業(yè)而言,礦工本是追求電費挖地的候鳥,面對遷徙早已習慣。
在監(jiān)管明確提出打擊比特幣開采之前,礦工也經(jīng)歷了一年兩季——豐水期和枯水期的遷移。豐水期在電費便宜的云貴川開采,枯水期在火電資源豐富的新疆、內(nèi)蒙古等地開采。
然而,隨著國內(nèi)監(jiān)管的日益收緊,礦業(yè)企業(yè)的下一次遷移可能只能是海外。
對于不同的礦企來說,大中型礦企仍然有海外布局的實力,小企業(yè)可能只能在政策收緊的情況下面臨關(guān)閉。
對于加快出海的大型礦山企業(yè)來說,美國、俄羅斯、哈薩克斯坦可能是比較集中的選擇之一。
業(yè)內(nèi)人士指出,大型礦業(yè)公司尋求安全合法的礦業(yè)業(yè)務,更傾向于與上述地區(qū)最大的托管公司談判。俄羅斯和哈薩克斯坦給出的礦業(yè)價格相對穩(wěn)定公平,這些地區(qū)溫度低,可以節(jié)約礦機散熱成本,非常適合礦業(yè)。
具體來說,俄羅斯和哈薩克斯坦每臺礦機的平均托管價格約為0.047-0.049美元(約為0.3-0.31元),包括管理和維護費用,但不包括維修費用。
對于像美國這樣的北美地區(qū),一方面政策穩(wěn)定,合規(guī)化程度高;另一方面,一些礦業(yè)企業(yè),比如比特大陸之前就有其他的業(yè)務,所以把它們的礦機和產(chǎn)業(yè)轉(zhuǎn)移到北美會比較方便。
有貨幣圈人士告訴21世紀經(jīng)濟報道記者,出海礦業(yè)并不容易。國外電費表面比國內(nèi)便宜,但環(huán)保成本很高。虛擬貨幣礦機的清洗機該特別拉過去,甚至機器的貨架也應該從中國進口。只要不走私,成本就會增加。目前,世界上70%的礦機都在中國生產(chǎn),物流和關(guān)稅將是未來礦山出海不可避免的命題。
盡管現(xiàn)在已經(jīng)有了專門的服務提供商,幫助礦山把機器轉(zhuǎn)移到國外。但是對小型礦山而言,這些繁瑣的手續(xù)、費用恐怕它們無法承受的。另外,就海外運營而言,礦機維修、適應海外工作人員的工作時間、當?shù)氐陌踩伟驳戎T多問題也將挑戰(zhàn)中國礦企的出海。
據(jù)報道,以前轉(zhuǎn)移到東南亞的中小礦場是受害者,大部分當?shù)氐V主都面臨損失。礦工表示,當?shù)鼐S護硬件成本和停機損失是中國的三倍;此外,電力的間歇供應和電網(wǎng)的頻繁故障導致成本上升和效率損失。同時,礦主也面臨著當?shù)厝撕屯械幕ㄊ脚e報。
因此,對于大多數(shù)國內(nèi)礦企來說,大家仍然期待著擁抱監(jiān)管,期待著政策的緩和。
一些礦工指出,畢竟對于中小型礦業(yè)企業(yè)來說,海外遷移很難實現(xiàn)。礦業(yè)企業(yè)只能期望走向合規(guī),低調(diào)采礦,不籌集資金,不炒作,不搞類金融產(chǎn)品,以及云計算中心、大數(shù)據(jù)中心、合規(guī)礦場等手續(xù)齊全的云計算中心、大數(shù)據(jù)中心、合規(guī)礦場,能否在符合能源政策的前提下,繼續(xù)備案。
然而,不可否認的是,雖然行業(yè)的具體文件尚未落地,但監(jiān)管對比特幣和比特幣開采的監(jiān)管方向和方向已經(jīng)逐漸明確,許多龍頭礦企正在加快海外轉(zhuǎn)移,中國礦企的出海潮正在到來。
目前市場上芯片短缺,這是因為現(xiàn)在虛擬幣市場火爆,雖然目前有所下跌,但總體來講還算好。如果現(xiàn)在還想投身挖幣事業(yè)分一杯羹,那么你需要的除了各種顯卡與電腦設(shè)備之外,還需要一些支持高速流通的網(wǎng)絡(luò)設(shè)備,因為挖礦所需要的除了芯片的算力,還需要龐大的網(wǎng)絡(luò)數(shù)據(jù)流通通道。選購一些有質(zhì)量保證的高速網(wǎng)絡(luò)設(shè)備可以使你的挖礦事業(yè)事半功倍,如虎添翼。
就網(wǎng)絡(luò)設(shè)備而言,奧卡斯科技擁有一條線延續(xù)(從網(wǎng)線到光纜到數(shù)據(jù)中心),在國內(nèi)建立了一條龍的營銷和售后服務運營體系。奧卡斯通過了ISO9001(2008)質(zhì)量管理體系認證。開發(fā)了6種以上系統(tǒng)的UTPCat.6A屏蔽布線系統(tǒng),滿足大數(shù)據(jù)中心的需求,同時通過了多個檢驗機構(gòu)的質(zhì)量檢驗認證,在美國、歐洲、馬來西亞、瑞士、德國、中東、南非等國家設(shè)立了自主品牌的聯(lián)絡(luò)處和銷售處,在30多個國家和地區(qū)提供了OEM服務,提供了全球化的產(chǎn)品服務。
奧卡斯科技是集銅纜接線、光纜接線、智能電子接線架解決方案、數(shù)據(jù)中心MTP/MPO高密度解決方案、數(shù)據(jù)中心冷通道解決方案、數(shù)據(jù)中心八種銅纜解決方案、安全電纜和智能管理接線系統(tǒng)平臺等產(chǎn)品自主開發(fā)、設(shè)計、生產(chǎn)、銷售于一體的高新技術(shù)企業(yè)。公司以追求用戶需求為導向,為客戶提供奧卡斯特有魅力的產(chǎn)品。奧卡斯布線四色方便!